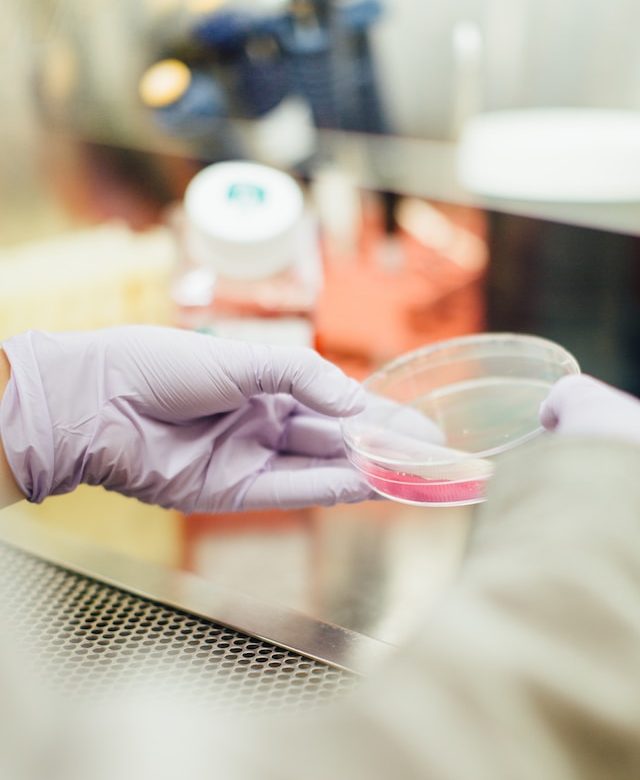

A Taste Sensation: Discover the Magic of Chicken and Olives
When it comes to salads, finding the perfect combination of ingredients that not only adds
Read More